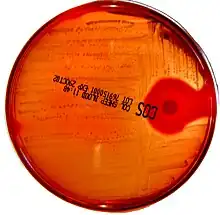

Gélose Columbia au sang
La columbia au sang est un milieu de culture et d'isolement de bactéries non exigeantes n'ayant pas besoin de facteurs particuliers, comme Streptococcus.
Culture de Streptococcus pyogenes sur Columbia au sang.
Composition
- Mélange spécial de peptones : 23 grammes,
- amidon : 1 g,
- chlorure de sodium : 5 g,
- agar : 10 g,
- sang : 50 mL.
Le potentiel hydrogène (pH) est de 7,3.
Préparation
42,5 g par litre. Stérilisation classique. Le sang est ajouté stérilement dans le milieu stérile en surfusion. On peut réaliser une gélose au sang cuit si le milieu est maintenu à 75-80 °C.
Lecture
L'hémolyse est la destruction des globules rouges :
- colonies entourées d'un halo clair : béta-hémolyse (hémolyse totale);
- colonies entourées d'un halo verdâtre : alpha-hémolyse (hémolyse partielle) ;
- autres colonies : gamma-hémolyse (absence d'hémolyse) .
Cet article est issu de Wikipedia. Le texte est sous licence Creative Commons – Attribution – Partage à l’identique. Des conditions supplémentaires peuvent s’appliquer aux fichiers multimédias.